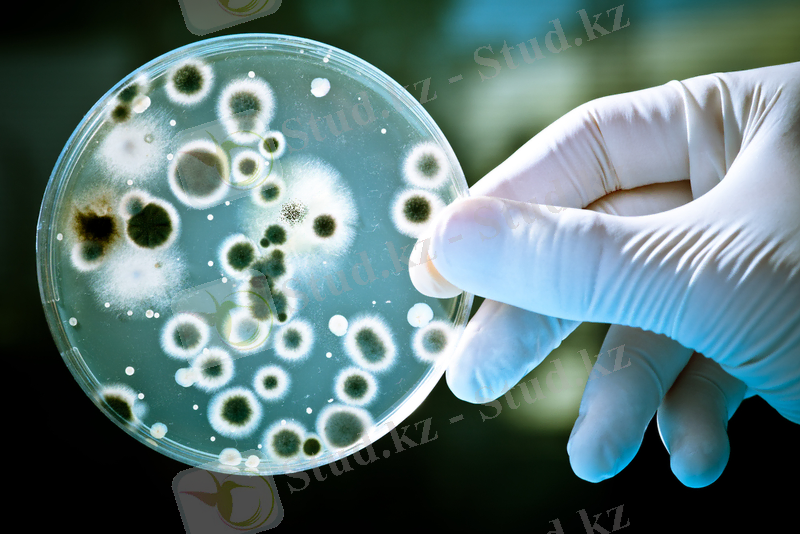

Инфекция формалары және олардың сипаттамасы: негізгі көздері мен жұғу жолдары



Студенттің өзіндік жұмысы
Факультет : Жалпы медицина
Дисциплина : Микробиология және иммунология
Курс : 2
Тақырыбы : Инфекция формалары жане олардын сипаттамасы. Инфекциянын негизги коздери, тасымалдау жолдары
Орындау әдісі : реферат
Орындаған: Базарбаева А. А.
Тобы: 202 «А»
Тексерген: Мусабаева С. Ж.
Ақтөбе қаласы, 2018
Жоспар
1 Кіріспе
2 негізгі бөлім
А) Инфекциялардың жіктелуі формалары, сипаттамасы
Б) Инфекцияның негізгі көздері
В) Тасымалдау жолдары
3 Қорытынды
4 Пайдаланылған әдебиеттер
Кіріспе
«Инфекция» - латын тілінен аударғанда жұқтыру деген ұғым береді. Инфекция дегеніміз эволюциялық процесс барысында биологиялық құбылыс ретінде қалыптасқан макро- және микроорганизмдер арасында өзара қарым-қатынасты анықтайтын күрделі процесс.

Инфекциялық процесс патогенді микробтар (ауру тудыратын) әсерінен макроорганизмде туатын күллі процестер мен физиологиялык және патология-лық реакциялардың жинағын сипаттайды. Ол тізбекті түрде дамиды және организмде болатын биохимиялық, цитохимиялық, морфологиялық өзгерістер-дің күрделі жинақ-түйіндерінен құралады. Инфекциялық процестің өзіне тән сипаттамасы болады.
Инфекциялық немесе жұқпалы ауру инфекциялык процестің клиникалық көрінісі ретінде қаралады және бірқатар клиникалық симптомдармен (белгілермен) сипатталады. Бұл аурудың өзіне тән клиникалық белгілері болады.
НЕГІЗГІ БӨЛІМ
Инфекцияны екі топқа бөледі:
а) Манифестті инфекция типті, атипті, созылмалы т. б. түрінде өтетін
инфекциялық ауру;
б) Симптомсыз инфекция - тасылдаушылық, латентті, абортивті,
Инфекцияның негізгі көздері. Адамның жұғу жолдары мен механизмдері
Инфекция негізгі үш көзі бар: адам (науқас, реконвалесцент, бактерия тасымалдаушы), жануарлар және сыртқы орта объектілері. Науқас адам немесе жануар сыртқа шығарған продуктілермен бірге шыққан кей патогенді бактерияларына сыртқы орта объектілері олардың тіршілік етуіне табиғи орталар болып келеді. Осыған байланысты жұқпалы аурулар бөлінеді: антропонозды (адам ғана ауырады, мысалы, іш сүзегі, дизентерия, тырысқақ т. б. ) ; зоонозды (жануарлар ауыратын ауру, мысалы, ірі қара малдың обасы, шошқа обасы, т. б. ) ; зооантропонозды (жануарлар ауырады, ал олардан адамдарға жұғады) . Зооантропонозды аурулардың 100 түрі анықталған (оба, туляремия, бруцеллез, лептоспироз т. б. ), кей түрлерінің -- табиғаттық ошақтары сақталып тұрады. Себебі, ауру қоздырғьшы қансорғыш бунақ аяқтылармен тасымалданып отырады, олар организмінде қоздырғыш ұзақ уақыт сақталуы мүмкін, кей кезде өмір бойы және ұрыққа трансовариалды жолмен беріледі. Осындай табиғи ошақтар, мысалы, кей риккетсиоздар, туляремия, вирустық энцефалиттер т. б. аурулар иксодов, гамазов, қызыл бұзау кенелермен және басқа қансорғыш бунақ аяқтылармен берілетіндер көп елдерде кездеседі. Олардың ұзак уақыт сақталуы қосымша екінші резервуары болуында, ал басқалары бірге өмір сүру кезінде сақталып отырады. Сондықтан, табиғи ошақта қоздырғыштың тұрақты айналымы сақталуы: науқас жануар-->қансорғыш бунақ аяқтылар (немесе сыртқы ортаның түрлі факторлары) ->сау жануарлар, көптеген аурулардың табиғи резервуары. Адам осы айналымға тіркелуі, қан сорғыштар шағуы кезінде жұғуы мүмкін немесе науқас жануарға тура және тура емес жолдармен байланысқанда. Осындай табиғи эндемиялық ошақтарға басқа жақтан көшіп келген адамдарға қауіп төнуі мүмкін, себебі бұрыннан тұратындар ертеде ауырып осы ауруларға тұрақты иммуиитет қалыптастырған.
Инфекциялык процестің негізгі факторлар қасиетгері бойынша (яғни коздырғыш пен макроорганизм) инфекцияның негізгі формалары аныкталған:
1.
Абортивті форма. Қоздыргыш организмге енеді, бірақ онда ол көбеимейді (организмнің табиғи төзімділігі мұқтаж болғандықтан немесе қоздырғышты тежейтіп пайда болған спепификалы иммунист нәтижесінен) . Сондыктан инфекциялық процесс дамымайды, ал коздырғыш ерте немесе кеш уакытта өледі немесе организмнен шығады.
2.
Латентті (инаппарантты) форма. Қоздырғыш организмге енеді, онда ол көбейеді, оның салдарына макроорганизм иммунобиологиялык реакция түрінде жауап қаитарып, иммунитет пайда болады және қоздыргыш организмнен шығады. Бірақ организмде инфекциянын клиникалық көріністері байқалмайды, олар корінбей өтеді (латентті) . Адамдар жиі латентті түрде полиомиелит, бруцеллез, вирустық гепатиттің кей түрлері және басқа аурулары өтеді.
3.
Ұйқылы инфекция. Латентті инфекциядан соң немесе аурудан сауыққан соң қоздырғыш организмде симптомсыз түрінде ұзақ уақыт сақталуы мүмкін. Мысалы, өкпе туберкулезі кезінде. Егер организмнің төзімділігі төмендесе, онда сақталып қалган қоздырғыш активтеніп көбейеді, нәтижесінде ауру немесе рецидиві (қайта қозуы) байқалады. Сондықтан, патогемді микроорганизмдер организмде ұйқылы жағдайда болуы мүмкін. Осындай ұйқылы жағдайда. бірақ патогенді қасиеттері сақталган микроорганизмдер сыртқы ортадан түседі. Егер осы микробтар жергілікті ошақта сақталып қалса және сол жерде ауру тудыратын болса «фокальді иифекция» термині колданады (мысалы, кариесті тісте тоқтап қалған қабыну процесі, осы жерде - қоздырғыш ұйқылы түрде оған қолайлы жағдай туғанша сақталып қалады) .
4.
Нақты қоздырғышқа типті инфекция формасы. Қоздырғыш организмге енеді, сол жерде белсенді көбейіп, аурудың клиникалық көріністерін тудырады және циклды түрде отеді.
5.
Латентті форма. Қоздырғыш организмге енеді, онда ол белсенді көбейеді, организм оған иммунобиологиялық реакция түрінде жауап береді, нәтижесінде активті иммунитет қалыптасады. Бірақ аурудың клиникалық көріністері айқын көрінбейді, атипті түрде өтеді. Бұл жағдай қоздырғыштын патогенді қасиеттері әлсіз болуы немесе организмнің табиғи резистенттілігі (төзімділігі) жоғары болғандықтан, немесе антибактериалді емі қарқынды көмектескен немесе аталған факторлардың барлығы әсер еткен
Адамның жұғу жолдары
Адам патогенді микроорганизммен инфицирленуі тек зақымдалған тері мен көздің кілегей қабықтары, тыныс алу, асқазан-ішек тракті және несеп-жыныс жолдары арқылы байқалады. Зақымдалмаған теріден жұғу өте сирек кездеседі, себебі тері бетінен көптеген микроорганизмдер өте алмайды. Бірақ, өте ұсақ зақымданулар кездессе (құмырсқа шағуы, ине кіруі, микротравмалар т. б. ) инфицирлену себебі болады. Адам немесе жануар организміне микробтар ену жері - кіру есігі дейді. Егер кіру есігі кілегей қабығы болса, инфекцияның үш типі байқалуы мүмкін: эпителиалді клетка беткейінде микробтар көбееді; клетка ішіне енуі және сол жерде көбеюі; қоздырғыш енген соң организмде таралуы байқалады.
Адамға инфекция жұғуы келесі жолдармен беріледі:
1. Ауа-тамшы немесе ауа-шаң арқылы
Нәжістік-оралді. Қоздырғыш нәжіс немесе несеп арқылы бөлінеді, ал жұғу инфицирленген су немесе тағамдар организмге ауыз арқылы түседі.
Трансмиссивті, яғни қансорғыш бунақ аяқтылар шағуы арқылы.
Жанасу жолдары науқас адам, реконвалесцент, бактерия тасымалдаушымен тікелей контакт немесе бірге қолданған ластанған үй жиһаздары арқылы - тікелей емес контакт.
Жыныстық жолмен
Стерилді емес медицииа приборлары, әсіресе шприц т. б. қолдану арқылы
Тік жолмен, яғни анадан балаға плацента арқылы, туу кезінде немесе бірден туған соң.
Инфекция қоздырғышының кіру жерінен байланысты жұғу жолдары ауру дамуында едәуір роль атқарады, себебі кей қоздырғыштар түрлі жолмен организмгс ене алады. Мысалы, Ү. реstіs құмырсқа шағуы (бүрге) кезінде берілсе, оба бубон түрде жеңіл өтеді, ал егер ауа-тамшы жолмен жұғылса аурудың ауыр түрі - өкпелі оба дамиды. Тап осылай туляремияның клиникалық көріністері өтеді: бубонды немесе жаралы-бубонды (трансмиссивті жолмен қансорғыш бунақ аяқтылар" шаққанда), көзді-бубонды (көздің кілегей қабығы арқылы жұғуы), өкпелі (ауа-тамшы жолы) т. б. ; сібір түйнемесінде кездеседі - терілік, өкпелік, ішектік формалары.
Бірақ, басқа қоздырғыштарда, мысалы СПИД ауруында жұғу жолдары маңызды роль атқармайды: ауру барлық түрінде ауыр өтеді. Сонымен қатар, ішектік инфекция қоздырғыштары ең алдымен нәжіс-оралді жолмен беріледі, респираторлы аурулар қоздырғыштары - ауа-тамшы арқылы т. б.
Организмге енген қоздырғыш таралуы әр түрлі жолмен таралады, микроорганизм қасиеттері бойынша: жанасу жолмен, яғни бір клеткадан екінші клеткаға, лимфа немесе гемагогенді жолмен; кей микроорганизмдер жүйке жолдарымен таралады.
Сау адамның және жануардың қаны стерилді, себебі күшті антимикробты қасиеті қандағы комплемент жүйесі мен түрлі иммунокомпетентті клеткалар қызметімен артады. Бірақ, организмде инфекциялық процесс дамығанда қанға қоздырғыш немесе оның токсині түседі және олар ыдырағанда бөлінетін антигендері. Қан арқылы қоздырғыш организмде жиі таралады, яғни инфекциялық процестің жайылуы (генерализациясы) байқалады. Қоздырғыш немесе онып антигендері көп мөлшерде қанға түсуі лихорадкамен сипатталады, бұл бір жағынан қоздырғыш қанға түскенін көрсетеді, ал екіншіден организмнің қорғаныс қызметі артуын байқатады.
Қанға қоздырғыш, оның токсині және антигені түскендігі келесі сипаттамалар береді: антигенемия, бактериемия, вирусемия, сепсис, септикопиемия, септицемия, токсемия, токсииемия.
Антигенемия - қанда генотипі бөтен антиген және аутоантиген айналуы. Егер қанда осы антигенге антидене болса, олар құраған комплексті айналымды иммунды комплекс дейді АИК (антиген антидене), нәтижесінде организм антигеннен босайды. АИК арқылы антигендер организмнен шығады. Қандағы антигендер мен АИК түрлі серологиялық реакциялар арқылы анықтайды, мысалы бруцеллезде агрегат-агглютинация реакцияда анықтайды.
Бактериемия - айналымды қанда бактериялар кездесуі - макроорганизмнін табиғи барьерлер арқылы және қансорғыш бунақ аяқтылар шағуы арқылы қоздырғыш қанға түседі. Қансорғыш бунақ аяқтылар тарататын ауруларда (сыпной тиф, қайталамалы тиф, оба, туляремия, риккетсиоздар т. б. ), бактериемия - ауру патогенезінің негізгі сатысы. Қоздырғышты бір қожайын-нан келесіге беріп, қоздырғыш түрін сақтайды. Бактериемия себептері хирургиялық операциялар, травмалар, сәулелі ауру, қатерлі ісіктер, шарттыпатогенді микроорганизмдер тудырғаң- аурудардың ауыр түрі т. б. Сепсис, септикопиемияға қарағанда бактериемия кезінде бактериялар қанда тек тарала-ды, бірақ көбеймейді. Сондықтан, бактериемия - аурудың симптомы және оның бір кезеңі. Бактериемия диагнозы қоздырғышты гемокультурада анықтау немесе лабораторлы жануарлар қанында тапқанда дәлелденеді (қойылады) .

Вирусемия - вирустар қанда кездескенде айтады.
Сепсис, шіріген қан - ауыр геперализацияланған жедел немесе созылмалы адамның қызба ауруы, іріңді ошақтан тұрақты немесе арнайы мезгілде қанға қоздырғыш түсуі. Сепсис кезінде жалпы көріністері жергілікті өзгерістерге сәйкес келмейді және жаңадан іріңді қабыну ошақтар түрлі мүше мен тіңдерде кездеседі.

Бактериемияға қарағанда, сепсисте қанның бактерицидтік қызметі тежелген соң бактериялар қан және лимфа жүйелерінде көбееді.
Сепсис жиі іріңді ошақтар локализациясы генерализацияланғанда байқалады. Сепсистің этиологиясы түрлі болуы мүмкін. Жиі кездесетін қоздырғыштары - стафилококкалар, стрептококкалар, Еntегоbасtегіасеае және Рsеudоmопаdасеае тұқымдастығына жататын теріс грамды бактериялар, менингококкалар, басқа шартты-патогенді және патогенділігі әлсіз бактериялар және кей саңырауқұлақтар. Бірінші іріңді ошағы және қоздырғыштың енген жері бойынша белгілі пуэрпералді (туғаннан соң әйелде), отогенді, одонтогенді, аборттан соң, перитонеалді, жаралы, қүйіктен соң, ауыз куысты (стоматогенді), кіндіктік, уросепсис т. б. Нәресте сепсисі (пеонаталді сепсис) кездеседі, нәресте туу кезінде немесе жатырдың ішінде ұрықтың инфицирленуі. Сепсистің криптогенді түрі анықталған, бірақ бірінші іріңді ошағы белгісіз.
Септикопиемия - сепсистің бір түрі, организмнің жалпы интоксикация-сынан басқа іріңді метастазды ошақтар түрлі тіңдер мен мүшелерде кездеседі. қоздырғыш бір жағынан қанда және лимфа жүйелерінде көбейіп таралуда.

Септицемия - сепсистің бір түрі, метастазды ірінді ошақтар болмайды, ал. қоздырғыштың көбею жері тек қан мен лимфа жүйесі.


- Іс жүргізу
- Автоматтандыру, Техника
- Алғашқы әскери дайындық
- Астрономия
- Ауыл шаруашылығы
- Банк ісі
- Бизнесті бағалау
- Биология
- Бухгалтерлік іс
- Валеология
- Ветеринария
- География
- Геология, Геофизика, Геодезия
- Дін
- Ет, сүт, шарап өнімдері
- Жалпы тарих
- Жер кадастрі, Жылжымайтын мүлік
- Журналистика
- Информатика
- Кеден ісі
- Маркетинг
- Математика, Геометрия
- Медицина
- Мемлекеттік басқару
- Менеджмент
- Мұнай, Газ
- Мұрағат ісі
- Мәдениеттану
- ОБЖ (Основы безопасности жизнедеятельности)
- Педагогика
- Полиграфия
- Психология
- Салық
- Саясаттану
- Сақтандыру
- Сертификаттау, стандарттау
- Социология, Демография
- Спорт
- Статистика
- Тілтану, Филология
- Тарихи тұлғалар
- Тау-кен ісі
- Транспорт
- Туризм
- Физика
- Философия
- Халықаралық қатынастар
- Химия
- Экология, Қоршаған ортаны қорғау
- Экономика
- Экономикалық география
- Электротехника
- Қазақстан тарихы
- Қаржы
- Құрылыс
- Құқық, Криминалистика
- Әдебиет
- Өнер, музыка
- Өнеркәсіп, Өндіріс
Қазақ тілінде жазылған рефераттар, курстық жұмыстар, дипломдық жұмыстар бойынша біздің қор #1 болып табылады.



Ақпарат
Қосымша
Email: info@stud.kz